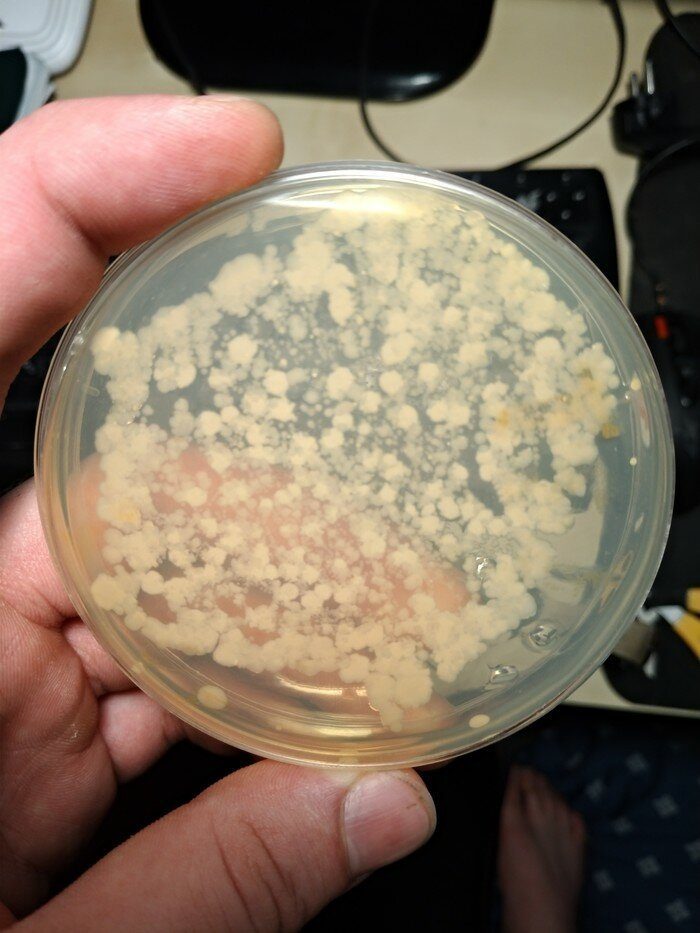

Суперкадры, которые удивят на 100%
Вам может казаться, что вас уже ничем не удивить и вы уже успели все повидать. Но это не так! Взгляните на эти снимки и откройте для себя нечто новое.
Биолог показал, сколько бактерий таит в себе кухонная губка. Он рекомендует прогревать ее 30 секунд перед мытьем посуды, чтобы уничтожить паразитов
Силиконовые импланты могут заменить бронежилет. Это в 2010 году доказала американка Лидия Карранс, в которую стреляли из пистолета. Пуля застряла в ее роскошном грудном импланте

В Канаде талую воду из ледников используют для создания элитной водки

Таяние Северного Ледовитого океана открыло новый морской путь, что снизило цены на доставку продуктов в северные страны
Задумывался ли ты когда-нибудь, как выглядит скафандр космонавта изнутри?

Белые медведи не боятся холода. Всё оттого, что шерстинки их меха внутри полые, как трубы. Это обеспечивает теплоизоляцию

Это вовсе не напечатанная на 3D-принтере модель, а вполне натуральный кристалл соли
Эта ужасающая махина — скелет кашалота

Когда ты задаешься вопросом, почему вода из крана течет так медленно, взгляни на фото известкового налета в водопроводной трубе
Лягушка светится, будто новогодняя гирлянда. Она проглотила сверчка

Вот на что способен всего один трудолюбивый бобер

Вот как выглядит попа пчелы, если посмотреть на нее под электронным микроскопом

А эта странная поверхность — голова пчелы

Смоляной молочай из Марокко способен уничтожить твои нервные окончания. Он острее привычных нам сортов перца в миллионы раз. Ученые собираются делать из него универсальное обезболивающее

Ночной кровопийца — комар под электронным микроскопом

Это вовсе не хоботок комара, а его сломанная нога. Оказывается, они полые внутри

А эта ужасающая колония микробов осталась после того, как чайник тщательно помыли. Приятного чаепития!

Картинка наглядно объясняет, почему нужно менять одноразовую иглу после первого же укола

Фото показывает, какие зоны у человека излучают больше всего тепла

Кажется, что это обычный листик. На самом деле это моллюск — единственное животное, у которого обнаружили способность фотосинтеза

Так выглядит кот в объективе тепловизора
Биолог показал, сколько бактерий таит в себе кухонная губка. Он рекомендует прогревать ее 30 секунд перед мытьем посуды, чтобы уничтожить паразитов
Силиконовые импланты могут заменить бронежилет. Это в 2010 году доказала американка Лидия Карранс, в которую стреляли из пистолета. Пуля застряла в ее роскошном грудном импланте

В Канаде талую воду из ледников используют для создания элитной водки

Таяние Северного Ледовитого океана открыло новый морской путь, что снизило цены на доставку продуктов в северные страны
Задумывался ли ты когда-нибудь, как выглядит скафандр космонавта изнутри?
Белые медведи не боятся холода. Всё оттого, что шерстинки их меха внутри полые, как трубы. Это обеспечивает теплоизоляцию

Это вовсе не напечатанная на 3D-принтере модель, а вполне натуральный кристалл соли
Эта ужасающая махина — скелет кашалота
Когда ты задаешься вопросом, почему вода из крана течет так медленно, взгляни на фото известкового налета в водопроводной трубе
Лягушка светится, будто новогодняя гирлянда. Она проглотила сверчка
Вот на что способен всего один трудолюбивый бобер

Вот как выглядит попа пчелы, если посмотреть на нее под электронным микроскопом

А эта странная поверхность — голова пчелы

Смоляной молочай из Марокко способен уничтожить твои нервные окончания. Он острее привычных нам сортов перца в миллионы раз. Ученые собираются делать из него универсальное обезболивающее

Ночной кровопийца — комар под электронным микроскопом

Это вовсе не хоботок комара, а его сломанная нога. Оказывается, они полые внутри

А эта ужасающая колония микробов осталась после того, как чайник тщательно помыли. Приятного чаепития!

Картинка наглядно объясняет, почему нужно менять одноразовую иглу после первого же укола

Фото показывает, какие зоны у человека излучают больше всего тепла

Кажется, что это обычный листик. На самом деле это моллюск — единственное животное, у которого обнаружили способность фотосинтеза

Так выглядит кот в объективе тепловизора
Только зарегистрированные и авторизованные пользователи могут оставлять комментарии.
0
По поводу таяния Северного полюса. Это фото из космоса? А что, наша планета так и выглядит, с обозначенными меридианами и параллелями?! ))
- ↓
0
Скафандр космонавта изнутри видел в экспозиции Московского Планетария в середине 80-х. Сейчас не знаю, стоит он там, или 90-е не пережил. :(
- ↓
+1
Здорово, что в северных странах подешевели продукты из-за таяния Северного Ледовитого океана. Может и у нас, южан, они когда-нибудь подешевеют.
- ↓
0
Просто мы, видать, глобального похолодания ждём… Назло всем)))))))))))
- ↑
- ↓
+1
Благодарю, Светочка ***
- ↓
0
Моллюск с фотосинтезом!
- ↓

